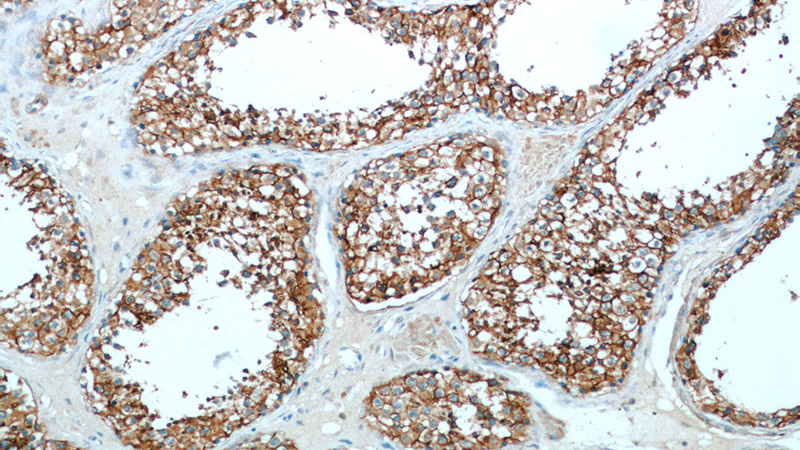
Immunohistochemical of paraffin-embedded human testis using Catalog No:109072(CCP1 antibody) at dilution of 1:50 (under 10x lens)
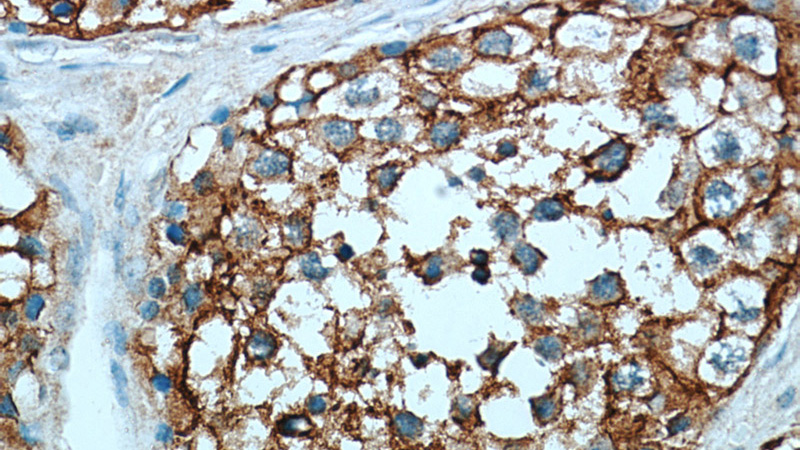
Immunohistochemical of paraffin-embedded human testis using Catalog No:109072(CCP1 antibody) at dilution of 1:50 (under 40x lens)

-
Product Name
CCP1 antibody
- Documents
-
Description
CCP1 Rabbit Polyclonal antibody. Positive IHC detected in human testis tissue, human heart tissue. Positive IF detected in A549 cells. Positive WB detected in A549 cells, mouse testis tissue. Positive IP detected in mouse testis tissue. Observed molecular weight by Western-blot: 138 kDa
-
Tested applications
ELISA, IHC, WB, IP, IF
-
Species reactivity
Human,Mouse,Rat; other species not tested.
-
Alternative names
AGTPBP1 antibody; ATP/GTP binding protein 1 antibody; CCP1 antibody; Cytosolic carboxypeptidase 1 antibody; DKFZp686M20191 antibody; KIAA1035 antibody; NNA1 antibody
-
Isotype
Rabbit IgG
-
Preparation
This antibody was obtained by immunization of CCP1 recombinant protein (Accession Number: XM_047423096). Purification method: Antigen affinity purified.
-
Clonality
Polyclonal
-
Formulation
PBS with 0.02% sodium azide and 50% glycerol pH 7.3.
-
Storage instructions
Store at -20℃. DO NOT ALIQUOT
-
Applications
Recommended Dilution:
WB: 1:200-1:2000
IP: 1:500-1:5000
IHC: 1:20-1:200
IF: 1:10-1:100
-
Validations

A549 cells were subjected to SDS PAGE followed by western blot with Catalog No:109072(CCP1 antibody) at dilution of 1:500

IP Result of anti-CCP1 (IP:Catalog No:109072, 3ug; Detection:Catalog No:109072 1:1000) with mouse testis tissue lysate 10000ug.
Immunohistochemical of paraffin-embedded human testis using Catalog No:109072(CCP1 antibody) at dilution of 1:50 (under 10x lens)
Immunohistochemical of paraffin-embedded human testis using Catalog No:109072(CCP1 antibody) at dilution of 1:50 (under 40x lens)

Immunofluorescent analysis of (-20oc Ethanol) fixed A549 cells using Catalog No:109072(CCP1 Antibody) at dilution of 1:25 and Alexa Fluor 488-congugated AffiniPure Goat Anti-Rabbit IgG(H+L)
-
Background
AGTPBP1, also known as CCP1 (cytosolic carboxy-peptidase 1), or Nna1, belongs to the peptidase M14 family. AGTPBP1 is a zinc carboxypeptidase that contains nuclear localization signals and an ATP/GTP-binding motiff. Thus, it may contribute to nuclear signaling events in differentiating and regenerating neurons. It serves important functions in the nervous system, and AGTPBP1 mutations may cause Purkinje cell degeneration (pcd) phenotypes.
-
References
- Kim N, Xiao R, Choi H. Abnormal sperm development in pcd(3J)-/- mice: the importance of Agtpbp1 in spermatogenesis. Molecules and cells. 31(1):39-48. 2011.
- Berezniuk I, Vu HT, Lyons PJ. Cytosolic carboxypeptidase 1 is involved in processing α- and β-tubulin. The Journal of biological chemistry. 287(9):6503-17. 2012.
- Rodríguez de la Vega Otazo M, Lorenzo J, Tort O, Avilés FX, Bautista JM. Functional segregation and emerging role of cilia-related cytosolic carboxypeptidases (CCPs). FASEB journal : official publication of the Federation of American Societies for Experimental Biology. 27(2):424-31. 2013.
- Herms A, Bosch M, Reddy BJ. AMPK activation promotes lipid droplet dispersion on detyrosinated microtubules to increase mitochondrial fatty acid oxidation. Nature communications. 6:7176. 2015.
- Kitano S, Kino Y, Yamamoto Y. Bioinformatics Data Mining Approach Suggests Coexpression of AGTPBP1 with an ALS-linked Gene C9orf72. Journal of central nervous system disease. 7:15-26. 2015.
Related Products / Services
Please note: All products are "FOR RESEARCH USE ONLY AND ARE NOT INTENDED FOR DIAGNOSTIC OR THERAPEUTIC USE"
